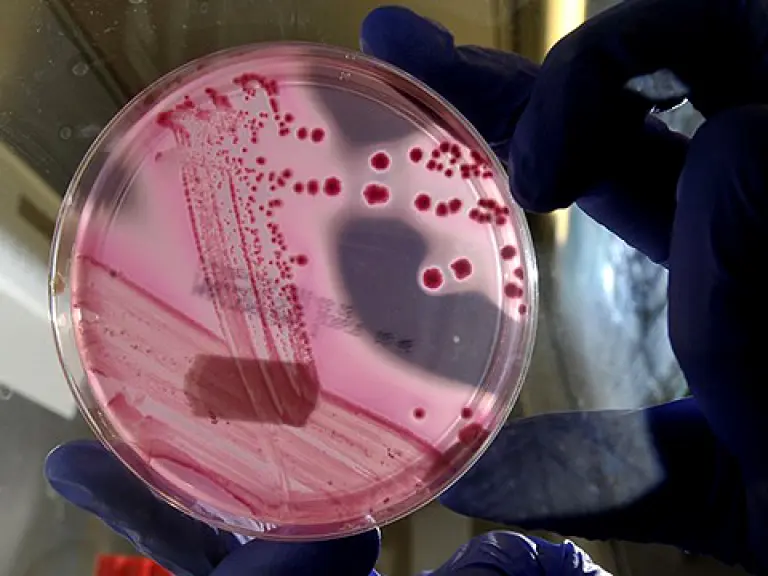
main image

Lectura 5:00 min
España no es causante de bacteria, reconoce Alemania
Alemania reconoció que los pepinos españoles no son los causantes del brote de E.coli en Europa, que ha causado la muerte de 16 personas y pérdidas por 200 millones de euros.
Bruselas.- Los gobiernos europeos intercambiaron acusaciones el martes sobre la fuente de un grave brote de la bacteria E. coli que ha provocado la muerte de 16 personas y enfermado a más de 1,000 en Alemania, Suecia y otros países de la región.
La bacteria mortal fue primero relacionada con pepinos españoles contaminados que habían sido importados por Alemania, pero funcionarios alemanes admitieron el martes que las últimas pruebas muestran que esos vegetales no portaban la peligrosa cepa de E. coli vinculada con el brote.
"Alemania reconoce que los pepinos españoles no son la causa", dijo el secretario estatal de Agricultura, Robert Kloos, durante un encuentro de ministros del sector agropecuario de la Unión Europea (UE) en Hungría.
EU INSPECCIONA PRODUCTOS DE ESPAÑA
En tanto, los funcionarios de salud de Estados Unidos están revisando los cargamentos de pepinos y otros productos frutihortícolas provenientes de España.
"Debido a la información recibida sobre el brote en Alemania, la FDA (Administración de Alimentos y Medicamentos de Estados Unidos) está marcando los cargamentos de pepinos, tomates y lechuga provenientes de España para su posterior inspección", dijo Doug Karas, portavoz de la agencia federal.
Karas añadió que estas clasificaciones para revisión comenzaron la semana pasada, y que la FDA seguirá inspeccionando la producción española hasta que surja más información sobre la causa del brote.
El brote de E. coli, uno de los mayores en su tipo, ha generado tensión diplomática entre Alemania, España, Francia y Rusia. Moscú prohibió las importaciones de algunos vegetales y amenazó con extender las restricciones a toda la UE.
La ministra de Agricultura de España, Rosa Aguilar, criticó la respuesta inicial de Alemania al problema.
"Alemania acusó a España de ser responsable de la contaminación con E. coli en Alemania, y lo hizo sin pruebas, generando un daño irreparable al sector productor español", mencionó Aguilar.
"Lo inmediato es resolver con aquellos países de la UE que estaban impidiendo la entrada de los productos españoles como consecuencia de la situación creada, por una acusación injusta, indebida y sin pruebas", añadió.
Medios españoles informaron que Alemania, Dinamarca, República Checa, Luxemburgo, Hungría, Suecia, Bélgica y Rusia están bloqueando la entrada de pepinos españoles en sus fronteras.
Aún se desconoce la fuente exacta de la contaminación con esta virulenta cepa de la bacteria, pero científicos indicaron que sospechan que es muy posible que los responsables sean vegetales porque el abono usado para fertilizar los campos puede portar E. coli.
La E. coli se puede adherir a la superficie de muchos productos frescos, como hojas de lechuga o de espinaca, o a los pepinos. Este tipo de E. coli sobrevive a las condiciones ambientales más adversas (...) y produce ciertas toxinas malas para los humanos", resaltó Brendan Wren, de la Escuela de Higiene y Medicina Tropical de Londres.
Expertos sanitarios del Centro Europeo para la Prevención y Control de Enfermedades (ECDC por su sigla en inglés), con sede en Estocolmo y encargado de monitorear las dolencias en la UE, identificaron la enfermedad como síndrome urémico hemolítico (SUH).
El SUH es una complicación grave de la llamada E. coli productora de la toxina Shiga (STEC), un tipo muy dañino de la bacteria.
PERDIDAS ESPAÑOLAS
El sector agrícola español indicó que está perdiendo alrededor de 200 millones de euros (unos 286 millones de dólares) semanales debido a la merma en las ventas. Aguilar señaló que Madrid pedirá "medidas extraordinarias para compensar las enormes pérdidas generadas al sector español".
El brote, que comenzó a mediados de mayo, ya enfermó a más de 1000 personas en Alemania, así como también a algunas personas en España, Suecia, Gran Bretaña, Dinamarca, Francia y Holanda que habían visitado recientemente el país germano.
Un turista estadounidense fue hospitalizado en República Checa con síntomas de infección por E. coli, luego de visitar Alemania.
En un nuevo signo de creciente tensión en Europa, el ministro de Salud francés, Xavier Bertrand, pidió mayor transparencia por parte de España y Alemania luego de que tres personas enfermaran en Francia.
"Primero las autoridades alemanas fueron categóricas", señaló. "Ahora están surgiendo cada vez más preguntas. Quiero saber el origen (de la contaminación)", añadió el ministro en la emisora televisiva France 2.
"Necesitamos información completamente transparente de las autoridades alemanas, y también de las autoridades españolas", consideró.
En Bruselas, la Comisión Europea indicó que "se están realizando esfuerzos por detectar todas las fuentes posibles de contaminación y ya se han obtenido resultados preliminares. Por lo tanto, cualquier prohibición sobre un producto sería desproporcionada".
En Holanda, en tanto, un grupo frutihortícola señaló que fueron paralizadas las exportaciones de pepinos a Alemania, su mercado más importante, por lo que sus productores están perdiendo millones de euros.
El síndrome urémico hemolítico o SUH afecta a la sangre, los riñones y, en los casos más graves, al sistema nervioso, y puede resultar particularmente serio en los niños y las personas mayores.
En un año promedio, en Alemania se registran 60 casos de SUH, informó el Gobierno.
APR